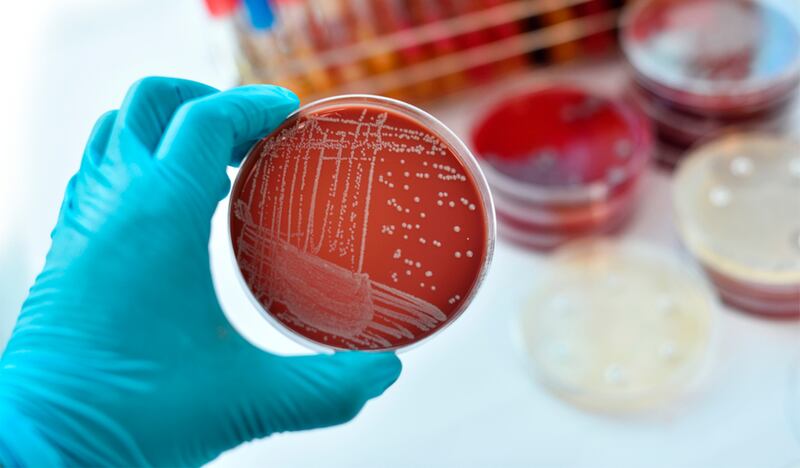

Una reciente investigación que unió las técnicas de reproducción asistida, tecnología y apoyo de la Inteligencia Artificial (IA) logró el nacimiento de un bebé sano de 38 semanas de gestación, además de obtener una tasa de fertilización del 80 por ciento.
Los investigadores lograron automatizar totalmente la técnica de micro manipulación de inyección intracitoplasmática de espermatozoides (ICSI, por sus siglas en inglés), un método que consiste en inocular un único espermatozoide en el ovocito maduro (células sexuales femeninas que se originan en los ovarios).
Aunque se permitió que el equipo necesario para la inyección fuera monitoreado o controlado de forma remota bajo supervisión médica.
El sistema se diseñó en el centro de investigación y desarrollo especializado Conceivable Life Sciences, Guadalajara, México, y en la ciudad de Nueva York mientras que el tratamiento experimental se realizó en una clínica de fertilidad ubicada en la misma ciudad jalisciense.
Se trató de una mujer de 40 años que presentó infertilidad primaria y reserva ovárica disminuida, quien junto a su pareja, un hombre de 43 años, buscaban tener un bebé mediante un método de fertilización asistida, después de que intentaron la fertilización in vitro y no tuvieran éxito.
Luego de realizar el procedimiento ICSI y el monitoreo constante se confirmó la fertilización. Según el estudio, el embarazo continuó sin incidentes, con un crecimiento fetal normal. No se reportaron complicaciones durante el parto por cesárea electiva, que resultó en el nacimiento de un niño varón sano a las 38 semanas de gestación.
La implementación de la IA en la técnica de fertilización asistida
De acuerdo con el artículo científico que expone los resultados del experimento, la IA fue la responsable de identificar el espermatozoide según la estructura morfológica, de modo que los clasifica en “cabeza y cuello” o “pieza media y cola”.
Lo anterior facilitó al equipo automatizado, la alienación precisa para la inmovilización del espermatozoide para su colocación en la aguja de la inyección para su posterior manipulación.
Otras Inteligencias Artificiales, desarrolladas internamente, se enfocaron primero en la identificación de los ovocitos y en determinar las posiciones para la alineación para la penetración de la aguja de la inyección con el espermatozoide que sería depositado.
Los investigadores precisan que el día del procedimiento participaron operadores remotos y doctores que estaban en una sala adyacente al laboratorio en donde se encontraba la paciente, y otros en Hudson, Nueva York, a casi 3 mil 700 kilómetros de distancia.







